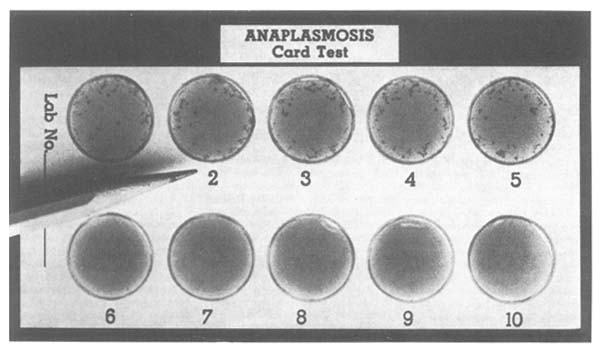

by T.E. Amerault and T.O. Roby
Bovine anaplasmosis, a tick- and insect-borne disease which causes extensive losses to the cattle industry throughout many regions of the world, can now be easily detected with a 10-minute card test at the farm or in the laboratory. For a better understanding of this test and its intended use, it would be desirable to review briefly some aspects of the disease.
Anaplasmosis is an infectious disease of dairy and beef cattle and certain wild ruminants such as blacktailed deer (Odocoileus hemionus columbianus). Signs of the acute disease include loss of weight, pale membranes, icterus, rapid respiration, decrease in milk flow, and constipation followed by diarrhoea. When the acute disease causes death, the gall bladder is enlarged, the spleen is two to three times its normal size, and anaemia is severe. Anaplasmosis is caused by a microscopic parasite of red blood cells known as Anaplasma marginale, and is transmitted by certain ticks and biting insects such as horse-flies (tabanids) and mosquitoes. A few species of ticks, however, are the only recognized biological vectors.
Prevalence and losses
In the United States the disease is prevalent in cattle herds in the south-eastern and southern central states from Delaware to the Texas-Mexican border and in the Rocky Mountain states. Because the disease is insect-transmitted, the losses are heaviest in the warmer regions of the United States and the world. As a result of interstate movements of cattle, anaplasmosis has now spread to most of the United States.
What anaplasmosis costs the world livestock industry is not known, but the figure must be staggering. Losses from the disease vary greatly. Mortality rates range from 5 percent in some herds where the disease has been prevalent for many years to as high as 70 percent during severe outbreaks in herds where the disease has not occurred previously. Though death losses are sometimes overwhelming, they can also be minor as compared with weight, milk, and calf losses among surviving cattle. McCallon (1973), in a U.S. survey of anaplasmosis based on complement fixation test results, estimated the loss to be U.S.$100 million annually. Because of the gigantic task of meeting world requirements for animal protein, such losses to beef and milk production can no longer be tolerated.
The authors are with the Animal Parasitology Institute, U.S. Department of Agriculture, Agricultural Research Service, Northeastern Region, Agricultural Research Center, Beltsville, Maryland 20705, United States.
Serologic tests for anaplasmosis
Losses from anaplasmosis need not be sustained because control or eradication of anaplasmosis is now possible. However, if such an endeavour is to be successful, the reservoirs of infection must be located and eliminated. At present we may not know every source of infection, but certainly 99 percent of the trouble originates from recovered cattle that serve as infected carriers. These reservoirs of anaplasmosis do not remain static. With the speed by which cattle can be transported today, the chance of disease spread is even increasing. Anaplasmosis-infected cattle can and should be identified, and the tools - serologic tests - for identifying infected cattle are now available.
A blood sample may be obtained from the tail vein of the animal to be tested.

Two such serologic tests for anaplasmosis are the complement fixation test and the card test. Of these the card test is the easiest to perform and requires a minimum of time and equipment. This test, which can be used as a rapid field test for anaplasmosis, is especially useful in range country where cattle roundup is expensive and time consuming, in sales yards where immediate test results are needed, and in wildlife surveys to detect anaplasmosis in animals such as deer. One can test 300 to 400 cattle per day on the farm and have the results 10 minutes after the last blood sample is drawn. The first method for conducting the card test is used at the farm for testing plasma from heparinized blood samples, and the second is used in the laboratory for testing serum from clotted blood samples. For testing at the farm, special equipment is required so that samples can be tested in a truck or other motor vehicle. The vehicle should have a heater and an air conditioner in order that a temperature range of 22 to 26°C can be maintained for the test. Also required are a centrifuge that can be plugged into the cigarette lighter and a 12-volt inverter that permits the card test rotator that normally works on 110 volts AC to operate on the 12-volt DC automobile system.
A small sample of blood (approximately 0.5 ml) is drawn from the animal's tail vein (or other suitable source) into a micro-blood plasma collector (a small plastic ampoule containing the anticoagulant heparin and fitted with a 20-gauge needle). The blood sample is centrifuged to separate the plasma and blood cells. A drop of antigen (killed Anaplasma parasites) and a drop of bovine serum factor (BSF = normal bovine serum containing specific amounts of bovine complement and conglutinin) are placed on a test card within each circle. A 0.03 ml sample of each plasma to be tested is then added to the circle with a calibrated capillary tube. The three drops of material (antigen, BSF, and plasma) are stirred together with a toothpick and further mixed by placing the test card on a rotator for precisely four minutes. Presence of the disease is indicated by visible, granular, blue-green clumps in the mixture (agglutination). If no clumps form, the test is negative. Complete and detailed instructions for conducting the card test may be found in a slide presentation booklet by Amerault and Roby (1976).
Only 0.5 ml of blood is required for the card test. This is drawn into a small plastic ampoule containing the anticoagulant heparin and fitted with a 20-gauge needle.

The time that elapses between obtaining the blood sample and testing the plasma or serum fraction from it is important. The plasma from heparinized samples should be tested within three hours after collection. Samples held longer often lose activity, and positive samples may become negative. Whole blood samples sent to the laboratory for testing should be allowed to clot and should remain at 22 to 26°C for 48 hours before testing because samples tested sooner often show false-positive reactions. When a significant delay in testing beyond 48 hours is anticipated, the samples should be stored frozen (-80°C).
The card test has been used throughout the United States since it was adopted by the Department of Agriculture in 1973 as an official test for bovine anaplasmosis. More than 200 veterinarians and technicians have been subsequently trained to perform and interpret the test and at least one laboratory in each state now has the requisite equipment and personnel. The test has been used as a diagnostic tool before treatment and as a survey aid in determining the prevalence of anaplasmosis in given areas.
Often the card test was used in conjunction with the complement fixation test for comparision. Both the card and the complement fixation tests were designed to detect carrier cattle and thus enable herd owners to free their herds of the disease or to test new additions and thus prevent their herds from becoming infected. Both tests are especially good for this latter purpose. The card test, the complement fixation test, and most other serologic tests do not always correctly classify acute cases. Blood smear examination is the method of choice for the diagnosis of acute cases because the causative organism can thus be detected before sufficient antibodies are produced to allow diagnosis by the card test or the complement fixation test. Infrequently the complement fixation test may detect a newly infected animal before the card test detects it, but usually there is no difference. In numerous trials, Anaplasma marginale can be routinely detected on blood smears from naturally infected animals about five weeks after exposure. Both card and complement fixation positive reactions usually occur five to eight weeks after exposure. With these limitations, the card test is a very useful, rapid and reliable technique in the diagnosis of anaplasmosis.
What can be done about anaplasmosis?
The question is frequently asked, “After I test and find that my cattle have anaplasmosis, what can I do about it?” Several things can be done:
The card test can be conducted at the farm. Special equipment, such as a portable centrifuge and rotator, is used so that samples can be tested in a truck or other motor vehicle.

Samples 1 to 5 with visible granular clumps (agglutination) are positive and indicate presence of the disease.
If there are many infected cattle, they should be separated from the healthy ones and the cattle maintained as two separate herds. Gradually, the infected cattle should be sold for slaughter as the individual situation permits. Although building a clean herd by this method takes time, it is better than doing nothing, incurs little expense, and stops disease spread.
All infected cattle could be treated with tetracycline added to the feed. Good results have been obtained by giving relatively high levels of the drug daily for about 60 days.
Low-level tetracycline feeding can be used in heavily infected herds, not as a cure, but to prevent new cases. The low-level dosage, about one tenth of the therapeutic level, aids in preventing the spread of anaplasmosis. Often the tetracycline is incorporated into a palatable, inexpensive mineral salt block. This antibiotic should be fed throughout the insect season, but in the United States it must be withdrawn 10 days before any cattle are sent to slaughter.
Vaccination of non-infected cattle also definitely aids in controlling death losses and the severity of anaplasmosis. One must realize, however, that after vaccination many cattle will remain positive to serologic tests indefinitely.
Application of insecticides to discourage ticks and biting insects should also be considered in controlling bovine anaplasmosis.
Test and treat programmes
The card test has been extensively evaluated in conjunction with treatment. One evaluation was conducted in the southern state of Alabama, where biting insects and not ticks are the principal vectors of the disease. In this study, Alley and Christenberry (1973) compared complement fixation test and card test results from 2 832 non-vaccinated cattle in seven anaplasmosis-infected herds. They found an overall agreement of 94 percent between the results of the two tests. The infected cattle were separated for treatment on the basis of the card test. The treatment consisted of tetracycline administered in the feed, or imidocarb diproprionate administered by injection; or, alternatively, card test-negative cattle were segregated from card test-positive cattle, and the latter were culled for slaughter as soon as possible. Results in this study show that anaplasmosis could be eliminated from herds by treatment or isolation exclusively on the basis of card test results.
In the coastal state of North Carolina, the horse-fly, of which there are about 100 species in the state, has been blamed for most of the anaplasmosis transmission. Because pastures from which carrier cattle are removed do not remain infective for normal cattle, a biological vector is not likely to be involved. The disease is handled on an individual herd basis upon request of the owner and the veterinarian. In one such herd, the initial card test showed that 95 percent of the cattle were infected. Testing continued, and all infected cattle were treated with tetracycline. Card testing and treatment were very successful, and this herd was the first in the state to be certified anaplasmosis-free. The success with which anaplasmosis has been controlled in individual herds suggests that the disease could be eradicated by a test and treat programme.
Wildlife reservoirs
In these successful test and treat programmes in Alabama and North Carolina there were no wildlife reservoirs of the disease, nor were ticks involved in its transmission. Unfortunately, this is not always the case. In the western states of the United States, deer are often thought to be reservoirs of anaplasmosis, and ticks may spread the disease. In Oregon, mule deer (Odocoileus hemionus hemionus) and Columbian black-tailed deer (Odocoileus hemionus columbianus) are found in pastures with cattle. In the central and eastern parts of the state, both the Rocky Mountain wood tick (Dermacentor andersoni) and the winter tick (Dermacentor albipictus) are indigenous. Both species parasitize cattle and deer. Peterson et al. (1973) conducted an investigation to determine: (1) whether natural infection and latent carriers occurred among mule deer ranging in enzootic anaplasmosis areas of Oregon; (2) the accuracy of the card test and complement fixation test conducted on mule deer serum; and (3) whether specimens of D. albipictus collected from mule deer could transmit A. marginale to susceptible calves. The results were negative in all three determinations. Blood from 31 mule deer was inoculated into susceptible calves. None of these calves developed anaplasmosis, although 22 of the deer were positive to the card test and two were positive to the complement fixation test. Furthermore, none of three susceptible test calves on which ticks taken from mule deer were allowed to feed developed anaplasmosis.
Two possible causes for the seemingly false-positive results of the card test in the Oregon mule deer survey are: (1) the mule deer may have been exposed to anaplasmosis and developed antibodies to the disease, but did not remain infected; and (2) card test antigen and some unknown antibody in the deer serum may have crossreacted.
The results obtained when the card test was used on serum from blacktailed deer in California were entirely different and most encouraging (Howarth et al., 1976). Ten deer were trapped and bled by jugular venipuncture. Another 25 deer were shot and bled immediately by cardiac puncture. Part of the blood sample from each deer was placed in a tube and permitted to clot for serum separation, and the rest was mixed with heparin to prevent clotting. Thirty-five Holstein steer calves, 2 to 3 months old, were inoculated with 15 to 70 ml of the heparinized blood from a single deer on a one-to-one basis. The time between blood collection and calf inoculation seldom exceeded one hour.
All deer serum samples were checked by card and complement fixation tests. Twenty-one samples were card testpositive and 14 were negative. Calf inoculations confirmed that the card test accurately detected the anaplasmosis status of each of the 35 Columbian black-tailed deer.
Other species of wildlife have been card-tested for anaplasmosis. Peterson and Roby (1975) used the card test on serum samples from 132 American bison but found no card test-positive results. The study lacked positive controls to determine the accuracy of the card test in relation to the bison because no known anaplasmosis-infected bison were available.
Card test for babesiosis
The card test has also been used on an experimental basis in countries other than the United States. In these countries, the test was used primarily as a survey tool to determine prevalence. The test is well suited for such use, and results have been most satisfactory. Many of these countries have cattle diseases causing greater losses than does anaplasmosis, e.g. babesiosis. Preliminary research indicates that a card test for babesiosis may also be feasible.
Todorovic and Kutler (1974) developed an antigen for use in a card test for bovine babesiosis. This test was very similar to the anaplasmosis card test, offered the same advantages, and was 100 percent in agreement with the complement fixation test. In cattle intentionally exposed to Babesia bigemina, the card test detected antibodies simultaneously with the onset of parasitaemia. Thus, the basic procedure of the anaplasmosis card test can probably be used to advantage for the rapid diagnosis of other haemotropic infections.
Summary
The advantages of a rapid, practical, economical and portable diagnostic test for anaplasmosis and other diseases are obvious. In this article the research, development and application of the card test for anaplasmosis have been reviewed. Extension of the application of the test for use as an epizootiological tool for determining wildlife reservoirs of anaplasmosis and for detecting babesiosis seems possible in the near future.
References
Alley, J.L. & Christenberry, C.C. 1973. An evaluation of the rapid card agglutination test for anaplasmosis in field diagnosis. Proceedings of the 6th National Anaplasmosis Conference: 137–140.
Amerault, T.E. & Roby, T.O. 1976. Slide presentation on card test procedures for bovine anaplasmosis. Beltsville, Md, U.S. Department of Agriculture, Agricultural Research Service, Animal Parasitology Institute.
Howarth, J.A., Hokama, Y. & Amerault, T.E. 1976. The modified card agglutination test: an accurate tool for detecting anaplasmosis in Columbian blacktailed deer. J. Wildl. Dis. (In press)
McCallon, B.R. 1973. Prevalence and economic aspects of anaplasmosis. Proceedings of the 6th National Anaplasmosis Conference: 1–3.
Peterson, K.J., Kistner, T.P. & Davis, H.E. 1973. Epizootiologic studies on anaplasmosis in Oregon mule deer. J. Wildl. Dis., 9: 314–319.
Peterson, K.J. & Roby, T.O. 1975. Absence of Anaplasma marginale infection in American bison raised in an anaplasmosis endemic area. J. Wildl. Dis., 11: 395–397.
Todorovic, R.A. & Kutler, K.L. 1974. A babesiosis card agglutination test. Am. J. vet. Res., 35: 1347–1350.
ANIMAL HEALTH YEARBOOK
ANNUAIRE DE LA SANTÉ ANIMALE
ANUARIO DE SANIDAD ANIMAL
1981

FAO - WHO - OIE